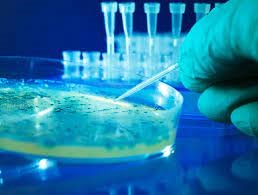

Tài liệu
CÓ PHẢI TẤT CẢ VI SINH VẬT ĐỀU HOÀN TOÀN CÓ HẠI?
Vi sinh vật là gì?
Vi sinh vật là tên gọi chung của những sinh vật có kích thước nhỏ bé mà mắt thường không nhìn thấy được, chỉ có thể quan sát chúng bằng kính hiển vi. Vi sinh vật gồm rất nhiều nhóm khác nhau: virus, vi khuẩn, nấm men, nấm mốc, protozoa, tảo…

Ảnh hưởng tiêu cực của vi sinh vật đến đời sống con người
- Gây hư hỏng thực phẩm
Hệ vi sinh vật thực phẩm được phát sinh từ nhiều nguồn khác nhau như thực phẩm bị nhiễm vi sinh vật từ môi trường bên ngoài, tay công nhân, dụng cụ, quá trình chuyên chở, bảo quản… hay thực phẩm bị nhiễm vi sinh vật từ chính bản thân nguyên liệu sản xuất nó.
Thực phẩm thường là những chất chứa nhiều nước, nhiều chất dinh dưỡng, vitamin và khoáng chất. Vì thế, đây là môi trường thuận lợi cho nhiều loài vi sinh vật có hại phát triển. Mỗi loại thực phẩm thường có một hệ vi sinh vật riêng và hoạt động của chúng gây nên những biến đổi sinh hoá, cơ lý trong thực phẩm và làm giảm chất lượng hoặc hư hỏng thực phẩm.

- Thực phẩm mang vi sinh vật gây bệnh
Khi chúng ta ăn phải các loại thực phẩm mang vi sinh vật gây bệnh hoặc độc tố của chúng sẽ gây ra nhiều bệnh cho cơ thể người có thể để lại hậu quả nghiêm trọng thậm chí dẫn đến tử vong.
Các bệnh thường gặp là thương hàn do vi khuẩn Salmonella thường có ở thịt gia cầm sống, trứng, thịt bò, rau quả, trái cây chưa rửa sạch, nếu không được điều trị đúng cách, Salmonella có thể lan rộng đến các cơ quan trong cơ thể, gây tử vong.
- Vi khuẩn tấn công con người
Vi khuẩn phần lớn là những vi sinh vật gây hại đối với con người, đó là do khả năng gây bệnh và lan truyền bệnh của vi khuẩn. Trên cơ thể người không có bộ phận nào mà vi khuẩn từ chối tấn công. Một số loại vi khuẩn có thể gây bệnh ở người, chẳng hạn như bệnh tả, bạch hầu, kiết lỵ, bệnh dịch hạch, viêm phổi, lao, thương hàn, và nhiều bệnh khác.
Vi khuẩn có lợi gì?
- Đối với cơ thể con người
Vi khuẩn trong hệ thống tiêu hóa giúp con người hấp thu các chất dinh dưỡng, chẳng hạn như đường phức tạp, được vi khuẩn chuyển hóa thành các dạng mà cơ thể có thể sử dụng. Một số vi khuẩn cũng giúp ngăn ngừa bệnh bằng cách chiếm những nơi mà vi khuẩn gây bệnh muốn gắn vào. Một số vi khuẩn bảo vệ chúng ta khỏi bệnh tật bằng cách tấn công các mầm bệnh.

- Trong công nghệ thực phẩm
Vi khuẩn axit lactic, như Lactobacillus và Lactococcus cùng với nấm men và nấm mốc, hoặc nấm, được sử dụng để chế biến các thực phẩm như phô mai, nước tương, natto (đậu nành lên men), giấm, sữa chua và dưa chua. Không chỉ lên men hữu ích để bảo quản thực phẩm, mà một số trong những thực phẩm này có thể mang lại lợi ích sức khỏe.
- Trong bảo vệ môi trường, dược phẩm và hóa chất
Một số vi khuẩn có thể phá vỡ các hợp chất hữu cơ. Điều này rất hữu ích cho các hoạt động như xử lý chất thải và làm sạch dầu tràn và chất thải độc hại. Các ngành công nghiệp dược phẩm và hóa chất cũng sử dụng vi khuẩn trong sản xuất một số hóa chất.
- Trong sinh học phân tử, sinh hóa và nghiên cứu di truyền
Do chúng có thể phát triển nhanh chóng và tương đối dễ thao tác, các nhà khoa học sử dụng vi khuẩn để nghiên cứu cách thức hoạt động của gen và enzyme. Vi khuẩn cũng là nhân tố cần thiết trong bào chế thuốc kháng sinh.
iLAB chuyên cung cấp các loại kính hiển vi hãng EUROMEX



Nguồn: tổng hợp
CÔNG TY TNHH ILAB Chuyên cung cấp các Thiết bị thí nghiệm cho ngành Dược phẩm và Mỹ Phẩm , các thiết bị phân tích chuyên sâu …v…v…
Nếu bạn vẫn còn thắc mắc nào cần giải đáp và cần sửa chữa chuyên nghiệp, hãy liên hệ với công ty iLAB qua Hotline: 02866525193 hoặc nhắn tin Zalo để được tư vấn và hỗ trợ nhanh chóng.




